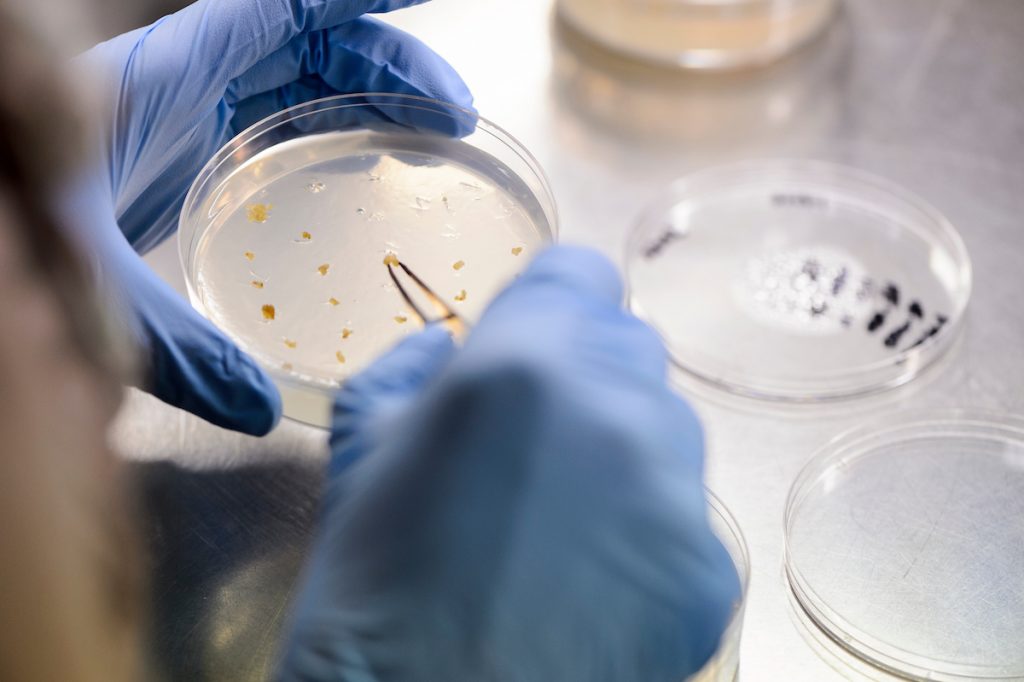

Finding that piece of research equipment just got easier
Have you ever tried looking for a needle in a haystack? Probably not, but you still might know what that feels like. UW-Madison is an expansive and complex campus with many moving parts. That makes it an exciting place to conduct research, but it also makes finding the resources you need to do your job a challenge at times.
Maybe you wanted to know if a certain cutting-edge technology was available on campus, or you were looking for expertise in high-speed digital circuits on campus. There has been no easy way to locate these resources.
Now that’s changed. On June 20, the Directory of Resources for Researchers opened its virtual doors and in less than three months, the directory has grown to include more than 650 resources and services, with more being added all the time.
The directory crosses all divisions — the biological, physical and social sciences, and arts and humanities. This scope makes the UW-Madison website unique among our peer institutions, whose efforts are typically limited to medical schools, biological or physical sciences.
The directory is the first centralized, publicly searchable directory of shared research resources, services and cores at UW-Madison. Information in the directory is organized using categories and keywords so related resources are easily located. The shared resources directory provides information about equipment and instruments, but also databases, technologies, services, training, expertise and consultation. Information in the directory also includes location, rate sheets, primary contacts for resources, and more. To date, the directory has had more than 1,400 unique users.
Resources for Researchers is a product of the Office of the Vice Chancellor for Research and Graduate Education. We are thankful to Dr. Isabelle Girard, director of the Office of Research Cores, for her leadership in the process and OVCRGE information technology support for developing the tool to make the directory a success right out of the gate.
Developing the directory was one of the recommendations of the cross-campus Working Group on Scientific Core Resources in 2014, and follows the model of our peer institutions. The framework was developed over a period of eight months through input from user inquiries and testing, particularly with new faculty members in a range of disciplines. The directory team used a model of continuous feedback to ensure alignment with researcher goals, and regular user testing will be used to make ongoing improvements.
We want this to be a value-added service that is transparent and easy to use, and enhances and expands the collaborative capabilities of the research community at UW-Madison.
If you need help locating a resource or if you would like to add a shared resource to the Directory of Resources for Researchers, please contact Isabelle at 608-890-4268 or Isabelle.girard@wisc.edu. (By the way, we need your help in expanding the directory. Please consider adding your shared resources to the directory and sharing information about the resource with your partners.) You also can sign up at the directory website to receive periodic summaries from the Office of Campus Research Cores on core service updates and new, shared resources. To learn more about the Office of Campus Cores visit research.wisc.edu.
We hope that this resource helps you move your research forward, without spending your valuable time searching for a needle in a haystack.
Rebecca Blank, Chancellor
Marsha Mailick, Vice Chancellor for Research and Graduate Education
This article was originally published on the Office of the Chancellor’s website.

